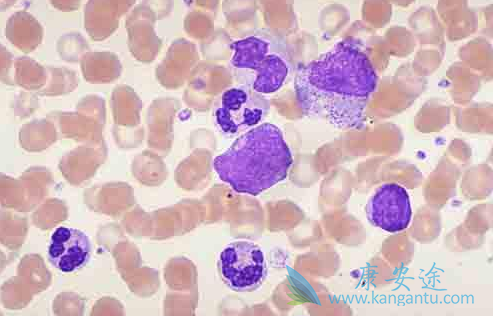
��Ѫ��

白血病是一种恶性很高的血液疾病,临床上常用的治疗白血病的药物有万珂、格列卫等。这些药物在白血病治疗上有非常好的疗效,然而在临床上,有很多白血病患者,在治疗期间因为蛋白质没有及时补充,结果病情越加严重。血液病专家表示,只有蛋白质足够才能够维持身体组织器官的正常工作,白血病机体内蛋白质的消耗量远远大于正常人,只有补充量多质优的蛋白质,才能维持各组织器官的功能。
所以白血病患者在治疗期间应以补充蛋白质应以优质蛋白为主。肝脏含有丰富的蛋白质,多种维生素和重要的矿物质等。每100克肝脏含蛋白质21.3克,比瘦肉高35%,比鸡蛋高30%。微量元素铁、硒和铜等在动物肝脏中含量也较丰富。此外,肝脏还含有较多的核酸,它在预防癌症中起着潜在的作用。白血病患者日常饮食中经常吃些动物肝脏,是有极大益处的。
因为白血病患者在格列卫、万珂等药物治疗期间,大多患者会出现恶性呕吐的问题,那此时患者饮食该注意些什么呢?此时可采取少食多餐的进食方法,或在三餐之外,增加一些体积小、热量高、营养丰富的食品,如糕点、巧克力、面包、猕猴桃、鲜蔬汁等。消化系统的不良反应,病人要多摄入碱性食物,以减轻消化道的不适。
详情请访问 肿瘤 https://www.kangantu.com/














请简单描述您的疾病情况,我们会有专业的医学博士免费为您解答问题(24小时内进行电话回访)